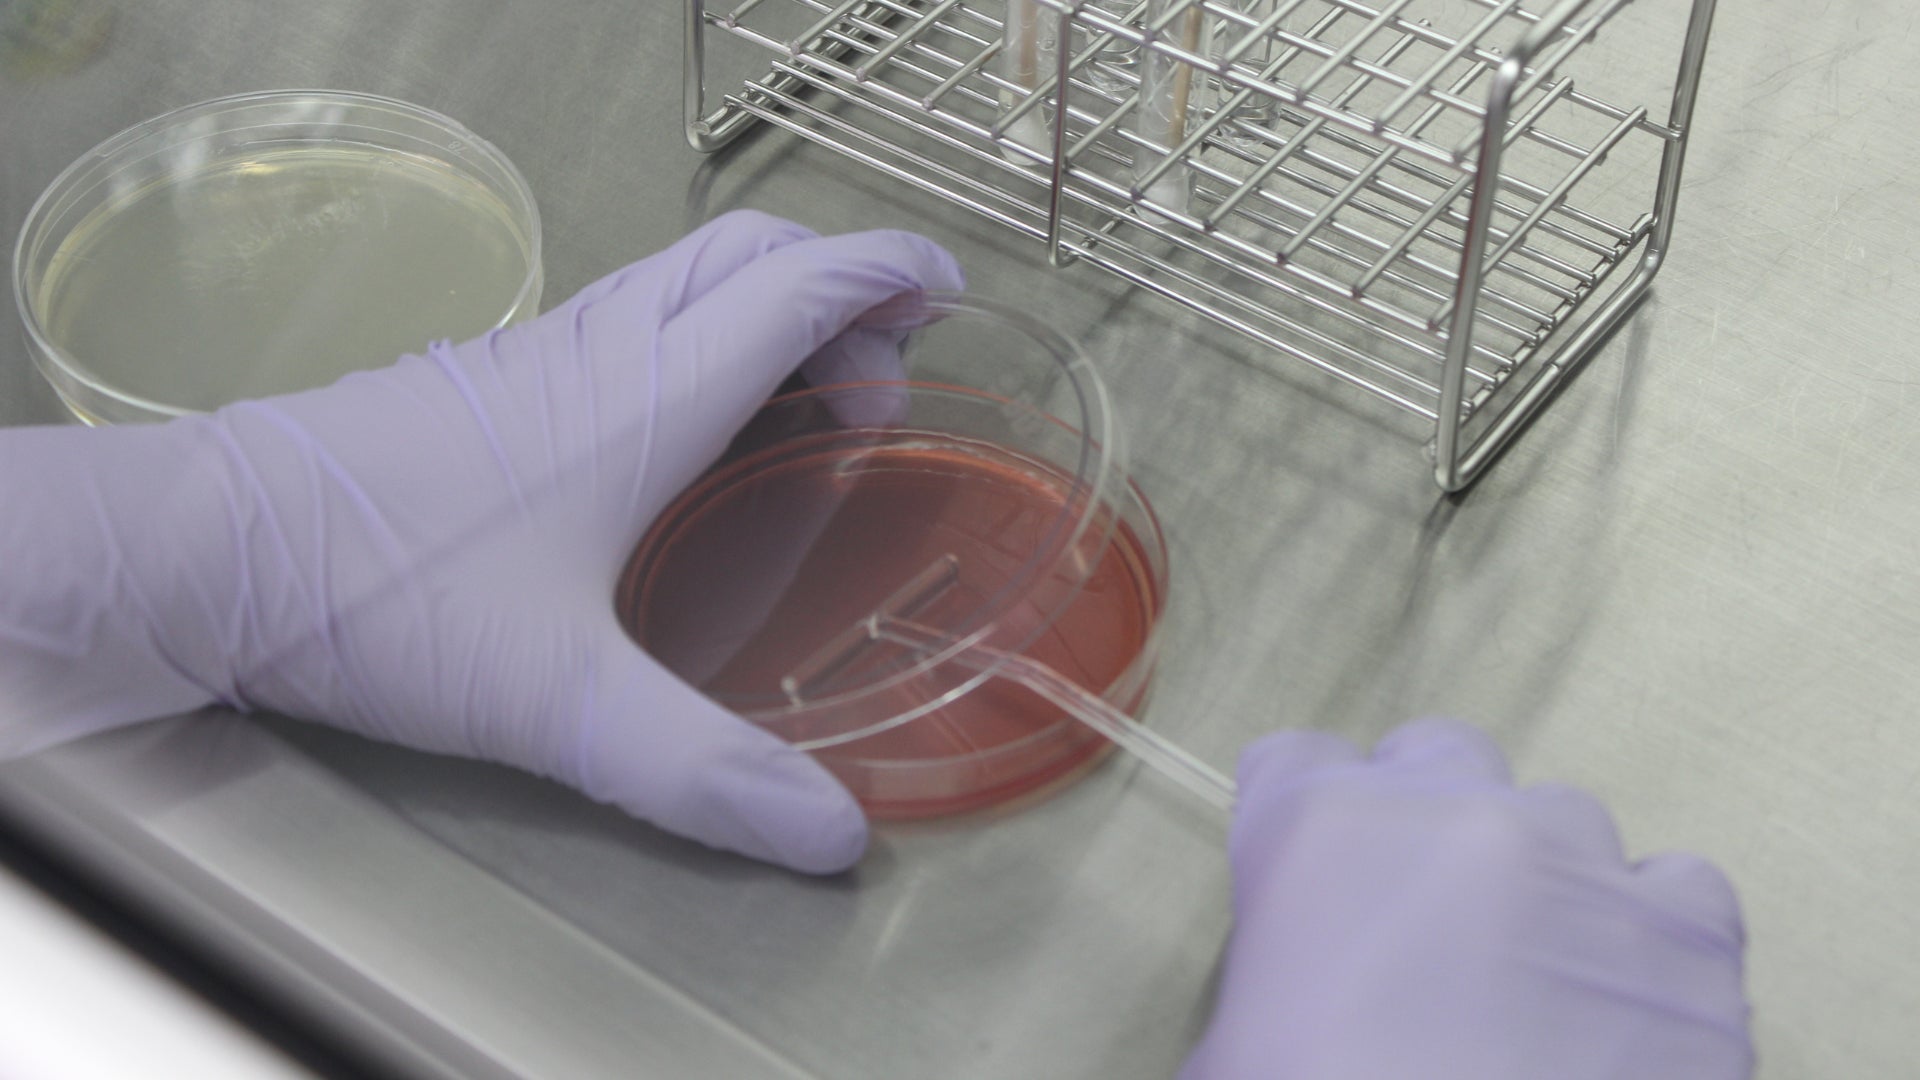

株式会社メディハオのプレスリリース

バイオスキンケア製品の開発を行う株式会社メディハオは、自社ブランド「MON BIOME(モンビオーム)」の供給体制の強化に伴い、販売代理店の募集を開始いたします。
これまで公式オンラインサイト限定で販売していたモンビオームは、毎月完売が続くなど大変多くの反響をいただいています。この度、提携研究所との連携拡大、専任スタッフの増員、受注システムの刷新など供給体制の強化を行い、全国の医療機関でもお取り扱いいただける体制を構築しました。
募集概要
l お取り扱いいただく製品
MON BIOME[モンビオーム]:https://monbiome.jp/
l 募集概要
-
募集対象:医療機関(美容皮膚科、美容外科、皮膚科、婦人科など)
-
募集院数:10院
-
募集地域:全国
-
契約形態:販売代理契約(完全受注生産制のため、在庫を抱えていただく必要はありません。)
l サポート体制
(1)導入準備
説明資料・院内販促ツール一式を無償提供し、オンラインでの導入支援を行います。初めてのクリニックでもスムーズにご案内できるよう、導入マニュアルや説明スクリプトも用意しています。
(2)教育研修
医師・スタッフ向けにオンライン研修会を定期開催し、製品理解からカウンセリングトークまで実践的にサポートします。
(3)販売促進
導入クリニックはMON BIOME公式サイトの「取扱院一覧」に掲載され、広報・PR連携を通じて露出を強化します。
(4)専任担当
導入後は各クリニック専任の弊社サポート担当者がつき、販売状況のフォローアップや運用面の相談対応を行います。医療機関様のキャンペーンや施策に合わせたご提案を随時実施させていただきます。
l 応募方法
下記URLのモンビオーム公式サイトのお問い合わせフォームよりご連絡ください。
https://monbiome.jp/pages/contact
製品概要
l MON BIOME[モンビオーム]とは?
モンビオームは、お客様ご自身の「美肌菌」から生まれるパーソナライズ美容液です。
ご注文後、まずお客様の肌に棲む美肌菌を専用キットで採取し、提携研究所にて丁寧に分析、そして培養いたします。培養された美肌菌を凍結乾燥によって粉末化してお客様のもとへお届けし、お客様の手で美肌菌をご自身の肌に戻すというスキンケアアプローチを採用しています。
– 製品情報 –
・価格:297,000円 (税込)
・内容量:24本 (3ヶ月分)
・原産国名:日本
– 特許 –
・日本:特許番号 第5584833号
・中国:特許番号 第2196526号
・韓国:特許番号 第10-1406808号



l 本製品の特徴

モンビオームの最大の特徴は、「お客様自身の美肌菌」を活用したパーソナライズド美容液であることです。一般的な美肌菌関連スキンケア製品は、美肌菌が減らないように肌を潤わせ整えることをコンセプトとしていますが、モンビオームはお客様の肌から採取した美肌菌を研究所で培養・増殖させ、再び肌へ届けることで、多くの美肌菌を肌に定着させることを目指しています。
お客様自身の美肌菌を用いているからこそ、安心してお使いいただけるのも大きな魅力です。
l 美肌菌のはたらき

美肌菌は、肌表面で皮脂や汗を分解し、グリセリンなどの天然の保湿成分や有機酸など、肌に有益な成分を生成することで、肌を健やかな状態 (弱酸性) に保ちます。
また、肌荒れの原因とされる「黄色ブドウ球菌」などの悪玉菌の増殖を抑える抗菌ペプチドも産生することで肌を制菌し、さらに脂肪酸の産生による抗炎症バリアも構築します。
l 使用方法

①キャップの開栓

②ゴム栓の開栓

③スパーテルで砕く

④化粧水と共に使用
l 製造工程
お客様のモンビオームは下の様な工程で製造されます。

01 / 皮膚常在菌の採取
お客様のご自宅等に採取キットを配送しますので、お客様ご自身で額から菌を採取していただき、研究所に検体を配送していただきます。

02 / 皮膚常在菌の培養
専門の研究スタッフにより皮膚常在菌の培養を開始します。

03 / 美肌菌のスクリーニング①
培養を進め、美肌菌や皮膚常在菌の確認を行います。

04 / 美肌菌のスクリーニング②
美肌菌の可能性のありそうな菌を選抜し、観察していきます。

05 / 美肌菌のスクリーニング③
菌をグラム染色し形態観察します。

06 / 美肌菌のスクリーニング④
美肌菌であることをPCRにて確定します。

07 / 美肌菌の薬剤耐性試験
薬剤耐性試験を行い、製品化する美肌菌に薬剤耐性がないことを確認します。
08 / 美肌菌の培養
確定した美肌菌を培養します。

09 / 美肌菌をバイアル瓶へ充填
培養した美肌菌をバイアル瓶へ充填します。

10 / バイアル瓶の美肌菌を粉末化し、完成
バイアル瓶に入った美肌菌を凍結乾燥し粉末化すれば、あなたの美肌菌でつくる美容液「モンビオーム」の完成です。

